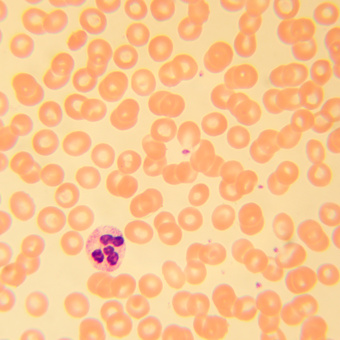
Микроскоп биологический MAGUS Bio 230T

Микроскоп биологический MAGUS Bio 230T
Биологический микроскоп MAGUS Bio 230T – это тринокулярная модель с ахроматической оптикой и галогенной подсветкой. Предназначен для изучения биологических срезов и мазков по методу светлого поля. Подходит как для рутинной лабораторной работы, так и для научных исследований. С дополнительными аксессуарами можно использовать больше методов исследований: темнопольный, фазовый контраст, поляризацию.
Задать вопрос
- Описание
- Характеристики
- Отзывы
- Задать вопрос
- Дополнительно
-
Описание
Биологический микроскоп MAGUS Bio 230T – это тринокулярная модель с ахроматической оптикой и галогенной подсветкой. Предназначен для изучения биологических срезов и мазков по методу светлого поля. Подходит как для рутинной лабораторной работы, так и для научных исследований. С дополнительными аксессуарами можно использовать больше методов исследований: темнопольный, фазовый контраст, поляризацию.
Оптическая схема
Преимущество тринокулярной насадки в том, что у нее есть отдельный визуальный канал для установки цифровой камеры. Он расположен вертикально, поэтому камера более устойчива. Камера не включена в комплектацию и может быть приобретена отдельно. Окулярные тубусы можно вращать на 360° для подстройки высоты выходного зрачка под разный рост. На правом окуляре есть диоптрийная подвижка.
5-гнездное револьверное устройство повернуто «от наблюдателя», поэтому пространство над столиком свободно, а введенный в ход лучей объектив хорошо виден. После установки комплектных объективов одно гнездо остается свободным, оно используется для установки опционального объектива.
Оптика скорректирована на бесконечность и дает увеличение от 40 до 1000 крат в комплектации «из коробки». Дополнительные окуляры повышают верхний предел кратности до 1500, 1600 и даже 2000 крат.
Система освещения
Наблюдения ведутся в проходящем свете, источником освещения выступает 30-ваттная галогенная лампа. Ее мощности достаточно для получения яркого и контрастного изображения на любом объективе не только в светлом поле, но также в фазовом контрасте и в темном поле. Свет теплого спектра меньше утомляет зрение, а, значит, способствует более продуктивной работе в течение длительного времени.
Тонкую настройку освещения выполняют при помощи апертурной диафрагмы конденсора и полевой диафрагмы. Настройка освещения по Кёлеру значительно повышает яркость и читаемость изображения. В конденсоре Аббе, положение которого можно регулировать в двух плоскостях (вертикаль/горизонталь), есть слот для установки слайдера: темнопольного или фазового на выбор. С помощью слайдера переключение между методами наблюдений осуществляется быстрее и удобнее.
Механика
Предметный столик без выдвижной рейки удобен для работы. Перемещение препарата под объективом происходит плавно. Препаратоводитель можно снять, если это необходимо.
Настройку резкости можно проводить грубо или точно, есть настройка жесткости хода и блокировка для грубой фокусировки. Рукоятки настройки расположены по обе стороны корпуса коаксиально. Так как они находятся близко к основанию микроскопа, руки во время работы не нужно держать на весу – можно свободно положить их на стол. Ход фокусировки плавный, регулировка не требует усилий.
Аксессуары
Для микроскопа MAGUS Bio 230T разработаны полностью совместимые окуляры, объективы, конденсоры темного поля, устройства простой поляризации и фазового контраста, цифровые камеры. С их помощью можно максимально расширить возможности микроскопа.
Основные особенности:
• Тринокулярная насадка, вращение окулярных тубусов на 360° для регулировки высоты выходного зрачка
• Отдельный визуальный узел для установки цифровой камеры, диоптрийная коррекция на левом окулярном тубусе
• Объективы-ахроматы, корректировка на бесконечность, револьвер на 5 объективов
• Проходящий свет, галогенный осветитель мощностью 30 Вт, полевая диафрагма для настройки освещения по Кёлеру
• Конденсор Аббе со слотом для фазового или темнопольного слайдера
• Грубая и точная фокусировка – рукоятки расположены коаксиально, есть механизмы блокировки и регулировки жесткости для грубой фокусировки
• Большой выбор дополнительных аксессуаровКомплектация:
• Штатив со встроенным источником электропитания, источником проходящего света, механизмом фокусировки, предметным столиком, кронштейном конденсора и револьвером объективов
• Конденсор Аббе
• Тринокулярная визуальная насадка
• Объектив-ахромат, рассчитанный на бесконечность: 4x/0,10
• Объектив-ахромат, рассчитанный на бесконечность: 10x/0,25
• Объектив-ахромат, рассчитанный на бесконечность: 40x/0,65 (подпружиненный)
• Объектив-ахромат, рассчитанный на бесконечность: 100x/1,25 ми (подпружиненный)
• Окуляр 10x/18 мм с удаленным зрачком (2 шт.)
• Наглазник на окуляр (2 шт.)
• Светофильтр (4 шт.)
• Переходник под крепление C-mount для работы с камерой
• Флакон с иммерсионным маслом
• Сетевой шнур питания для микроскопа
• Пылезащитный чехол
• Инструкция по эксплуатации и гарантийный талонПоставляются по дополнительному заказу:
• Окуляр 10х/20 мм со шкалой
• Окуляр 15х/11 мм (2 шт.)
• Окуляр 16х/11 мм (2 шт.)
• Окуляр 20х/11 мм (2 шт.)
• Объектив-ахромат, рассчитанный на бесконечность: 20х/0,40
• Объектив-планахромат, рассчитанный на бесконечность: 20х/0,40
• Объектив-планахромат, рассчитанный на бесконечность: 60x/0,80 (подпружиненный)
• Фазово-контрастное устройство: фазовый конденсор, набор фазовых объективов, вспомогательный центрирующий телескоп
• Фазово-контрастное устройство: набор фазовых слайдеров, набор фазовых объективов, вспомогательный центрирующий телескоп
• Конденсор темного поля А 0,9
• Конденсор темного поля иммерсионный А 1,36–1,25
• Слайдер темного поля
• Устройство простой поляризации
• Цифровая камера
• Калибровочный слайд
• Монитор -
Характеристики
Бренд MAGUS (Магус) Гарантия, лет 5 лет EAN 5905555017938 Размер упаковки (ДxШxВ), см 43x27x63 см Вес в упаковке, кг 10.5 кг Тип биологические, световые/оптические Тип насадки тринокулярная Насадка Gemel (Зидентопф с вращением тубусов на 360°) Угол наклона окулярной насадки 30° Диапазон увеличения, крат 40 — 1000 Диапазон увеличения от 800x до 1280x Увеличение, крат (опционально) 40–1500/1600/2000 Диаметр окулярной трубки, мм 23.2 Окуляры 10х/18, удаленный зрачок 10 мм (*опция Объективы ахроматические, скорректированные на бесконечность Револьверное устройство на 5 объективов Рабочее расстояние, мм 18,89 (4x); 5,95 (10x); 0,775 (40xs); 0,36 (100xs); 2,61/8,80 (20х); 0,46 (60хs) Межзрачковое расстояние, мм 48 — 75 Предметный столик, мм 180x150 Диапазон перемещения предметного столика, мм 75/50 Характеристики предметного столика двухкоординатный механический, без выдвижной рейки Возможность диоптрийной коррекции, D ±5 (на левом тубусе) Конденсор центрируемый и регулируемый по высоте конденсор Аббе NA 1,25 с регулируемой апертурной диафрагмой и слотом для слайдера темного поля и фазового контраста; тип крепления «ласточкин хвост» Диафрагма регулируемая апертурная, регулируемая ирисовая полевая Фокусировка коаксиальная, грубая (21 мм, 39,8 мм/оборот, с механизмами блокировки и регулировки жесткости) и тонкая (0,002 мм) Подсветка галогенная Регулировка яркости Да Источник питания 220±22 В, 50 Гц, сеть переменного тока Тип лампы подсветки 12 В/30 Вт, цоколь G4 Светофильтры есть Диапазон рабочих температур, °С 5 — 35 Возможность подключения другого оборудования фазово-контрастное устройство (конденсор и объективы), конденсор темного поля (сухой или масляный), устройство простой поляризации (поляризатор и анализатор) Уровень пользователя для опытных, для профессионалов Уровень сложности сборки и настройки сложно Назначение лабораторные/медицинские Расположение подсветки нижняя Метод исследования светлое поле Чехол/кейс/сумка в комплекте чехол пылезащитный Вес, кг 8 Габариты, мм 200x436x400 ОтзывыЗадать вопросВы можете задать любой интересующий вас вопрос по товару или работе магазина.
Наши квалифицированные специалисты обязательно вам помогут.ДополнительноДополнительная вкладка, для размещения информации о магазине, доставке или любого другого важного контента. Поможет вам ответить на интересующие покупателя вопросы и развеять его сомнения в покупке. Используйте её по своему усмотрению.
Вы можете убрать её или вернуть обратно, изменив одну галочку в настройках компонента. Очень удобно.